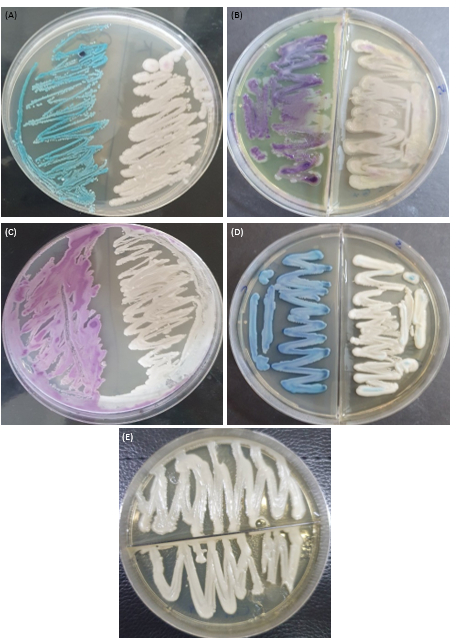
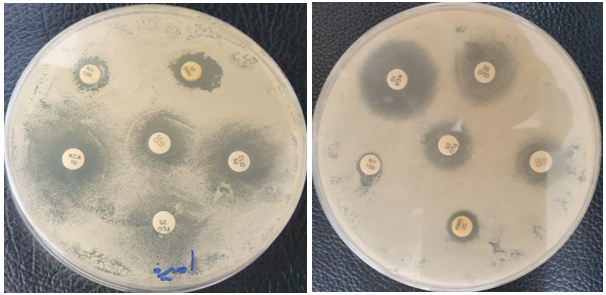

This study aimed to determine the distribution and antifungal susceptibility of Candida species isolated from 190 patients under chronic dialysis. During the period from November 2022 to the end of March 2023.Demographic, clinic data and urine samples were obtained. Candida spp prevalence was 24.2% of 46 isolates. Females had a higher infection rate than males, and the age group (41-50 years) was the most infected with Candida spp. Principal identified species were C. glabrata, C. krusei, C. parapsilosis, C. tropicals and C. albicans, which is considered the most common and frequent. The results showed that the antifungal ketoconazole (10 µg /disk) was most capable of inhibiting Candida isolates with a percentage of 89.1%, while the antifungal clotrimazole (10 µg / disk) and fluconazole (25 µg/disk) had the least ability to inhibit Candida isolates with a percentage of 67.4%. While it showed that the antibiotic amphotericin B had the highest resistance, while the antibiotic ketoconazole showed the least resistance to Candida isolates.
Candidiasis, caused by Candida spp, is the most common fungal infection in immunocompromised patients, resulting from overuse of antibiotics, immunosuppressive drugs in chemotherapy, organ transplantation, HIV/AIDS, and diabetes. All of these factors contribute to an increased incidence of candidiasis [1]. The global incidence of candidiasis has reached 750,000 cases annually [2], with approximately 200 species of yeast documented, including 20 pathogenic species for humans. However, 90% of candidiasis infections occur due to common species such as C. albicans, C. krusei, C. tropicalis, C. glabrata, and C. parapsilosis. These yeasts are part of the normal flora, living naturally in various sites of the human body. However, when the body's immune system is compromised, they transform into pathogenic fungi [3]. These species are characterized by possessing various virulence factors that facilitate their spread and infection of different sites in the human body [4].
Chronic kidney disease (CKD) is a condition in which the kidneys lose their ability to function normally. It can be caused by several factors, including infections, autoimmune diseases, diabetes, other endocrine disorders, cancer, and exposure to harmful chemicals [5]. Patients with chronic kidney failure undergoing regular dialysis sessions are more susceptible to opportunistic fungal infections, which can lead to bloodstream infections and are considered one of the leading causes of death in acute kidney failure patients [6,7]. They also suffer from a high incidence of anemia, malnutrition, and multifactorial immune deterioration [8]. On the other hand, hemodialysis (HD) is associated with long-term immune system suppression, affecting both cellular and humoral immunity [9,10]. Uremia is also linked to reduced phagocytic activity, increased programmed cell death in neutrophils, and depletion of regulatory T cells [11], making the immune system less effective and more susceptible to fungal infections [8].
The use of antifungal agents in humans can have side effects, including fever, chills, high blood pressure, and potential toxicity [12]. The role of antifungal agents can be twofold, either killing fungi or inhibiting their growth, but this effect may be limited to specific groups of fungi and not all types. Most antifungal agents currently used affect either the biosynthesis of the fungal cell wall or interfere with pyrimidine metabolism or interfere with sterol metabolism [13]. The immune mechanisms for defense against fungal infections are diverse, ranging from ancient protective mechanisms that are specifically triggered during
infection and disease [14]. So this result aimed to evaluate the sensitivity of the Candida spp to the some antibiotic.
Sampling
One hundred and ninety urine samples were collected from chronic dialysis patients in addition to 20 urine samples as control groups of both gender and different ages at Kirkuk Teaching Hospital in Kirkuk city, during the period from November 2022 to March 2023.
Isolation of Candida spp
All urine samples were cultured on SDA media, and incubated at 37 ℃ for 48 hours. Identified all fungal growth depended, color, size and morphology of the colonies [15].
Identification methods
Morphological Identification Candida spp.
Candida spp isolates were identified based on the developing colonies on SDA and that appear as smooth, glabrous, yeast-like structures that are white to cream in color [16].
Microscopically identification Candida spp
A portion of the fungal colony was taken and mixed with a drop of lactophenol cotton blue stain, then spread onto a glass slide. The sample was then examined under a light microscope at magnifications of X10 and X40 to observe pseudohyphae and budding [17].
CHROMagar Candida Media
Chrome Candida agar is a selective medium (Himedia, india) that is utilized for the identification of Candida spp. Samples were cultured on this medium, and each species displays a distinctive color. Petri dishes containing the cultured samples are then incubator at 37 ℃ for 48 hours. In order to identify the different the species of Candida [18].
Germ Tube Test
The method involves taking a portion of the colony and placing it in a test tube containing 0.5 ml of blood serum. The mixture is then incubated at 37 ℃ for 3 hours. After that, a drop of the suspension is taken and placed on a glass slide and examined under a microscope to observe the germ tube. This examination is distinctive for the C. albicans, C. dubiniensis, and C. stellatoidea [19].
Antifungal susceptibility test
The sensitivity test for yeast was performed using the disk diffusion method according to the Clinical and Laboratory Standards Institute (CLSI) guidelines, different antifungal agents and concentrations was used, including Nystatin (NY), Ketoconazole (KCL), Clotrimazole (CLO), Fluconazole (FLU), and Amphotericin B (AMB) (Liofilchem, Italy). A yeast suspension was prepared for each isolate, and the turbidity was measured to be between 1.8-2.20 using a McFarland. The suspension was then streaked onto the surface of SDA medium using a sterile loop. Antifungal disks were placed on the surface of the medium and then incubated at 37°C for 24-48 hours, with growth monitored. The results were recorded, and the diameters of the inhibition zones around the different antifungal disks were measured using a ruler [20].
The current study showed that females are more susceptible to Candidiasis compared to males and the percentage was 58.7%, 41.3% respectively. The highest percentage of Candidiasis occurred in patients age groups between 41-50 years (Table 1), which is in line with [21,22,23] who reported that most affected patients were over 45 years old. However, there is still no definitive relationship due to differences in population and racial samples. Renal insufficiency is associated with decreased immune function, leading to increased susceptibility to infections in these patients and immune activation, leading to inflammation [24, 25]. The results of urine culture on SDA media showed 46 positive samples, accounting for 24.2%, and 144 negative samples, accounting for 75.8%. No fungal growth was observed in the control samples (Figure 1).
The results of laboratory culture on differential medium CHROMagar Candida that used to identify Candida spp based on colony color indicated five species of the Candida. C. albicans, C. glabrata, C. kruzei, C. parapsilosis and C. trpicals as showen C. albicans was the most common isolate, accounting for 41.3% of isolates, characterized by green colonies on CHROMagar Candida. All C. albicans exhibited germ tube formation. This was followed C. glabrata 30.4 % with dark purple color, C. krusei 17.4 % with light pink color, C. parapsilosis 6.5 % with white color, and C. tropicalis 4.4 % with blue colonies. Non-albicans species were unable to form germ tube formation. These findings are consistent with the results of [26, 22], and [27, 28], but do not agree with the results of [29]. This phenomenon can be attributed to several reasons, including immunocompromised of the patients, making them more susceptible to urinary tract infections [30]. Additionally, the absence of a natural voiding mechanism plays a mechanical role in expelling pathogenic organisms. Furthermore, impaired kidney function leads to the inability to excrete substances in the urine that typically act as antimicrobial factors [31] (Table 2, Figure 2, 3).
Table 1: Demographic description of the study sample.
Variables | Number | % | |
Gender | Male | 19 | 41.3 |
Female | 27 | 58.7 | |
Age | 11 - 20 | 2 | 4.3 |
21 - 30 | 2 | 4.3 | |
31 - 40 | 8 | 17.4 | |
41 - 50 | 13 | 28.2 | |
51 - 60 | 7 | 15.2 | |
61 - 70 | 9 | 19.6 | |
71 - 80 | 5 | 10.9 | |

Figure 1: Percentage of Candida spp. isolated from urine samples
Table 2: The morphological and biochemical characteristics, of the isolated candida species.
Candida spp | On Sabouraud Dextrose Agar | Germ Tube | On CHROMagar Candida |
C. albicans | White creamy | + | Green |
C. glabrata | White creamy | ــ | Dark purple |
C. kruzei | White creamy | ــ | Light pink |
C. parapsilosis | White creamy | ــ | white |
C. trpicals | White creamy | ــ | blue |
*-: Negative, +: Positive
A study of antifungals activity conducted on five species of the most frequent Candida spp recognized as causative agents of Candidiasis C. albicans, C. glabrata, C. krusei, C. parapsilosis, C. tropicalis, by using the disk diffusion method and the study results showed that Ketoconazole was the most effective antifungal agent against Candida species, followed by Clotrimazole and Fluconazole (see Figure 4 and Table 3, 4). These results are consistent with [32] and [33]. However, although Azole antifungal agents are effective in inhibiting yeast growth, they Amphotericin B, which is consistent with [34] and [32]. They reported that Candida species C. glabrata, C. krusei, and C. parapsilosis were 100% resistant to Nystatin. However, these findings do not agree with [35], who reported that Candida species C. glabrata, C. krusei, C. parapsilosis, C. tropicalis, and C. albicans were sensitive to Nystatin. The results also did not agree with those of [36] when studying have negative side effects on the liver, as reported by [37]. On the other hand, the Candida species showed resistance to Nystatin and Candida spp, as they found that they were sensitive to Amphotericin B.
The azoles target is to act on inhibition of the enzyme cytochrome P450 oxidase, preventing the formation of an important compound called ergosterol in the fungal cell wall. This can cause gaps or tears in the cell wall. Additionally, this inhibition makes the Oxidation process to be disabled in the plasma membrane. The accumulation of phospholipids within the cell due to the effect of the antifungal agent on membrane composition can also contribute to fungal cell death [38].
Sensitivity test results for yeast can vary due to several factors, including the studied population, previous treatments taken by the patient, the patient's internal characteristics, excessive or incorrect use of antibiotics, and an increase in immunocompromised patients [39]. Other factors that may affect the results of antifungal sensitivity tests include the inoculum size, incubation period and temperature, and the medium used in the test [40]. The sensitivity test for antifungal agents plays a vital role in selecting the appropriate antifungal agent for treating fungal infections [41], which reduces morbidity and mortality rates among patients. Therefore, antifungal agents should be carefully selected after conducting accurate analysis and confirming the diagnosis [42]. The indiscriminate and frequent use of antibiotics is considered to contribute to the emergence of new resistant strains of Candida spp. For this reason, it is expected that these species of Candida spp. may differ from one type to another. Additionally, these species may also vary based on the source from which they were collected [43].
Figure 2: Candida spp on Chrom Candida Agar and SDA, A C. albicans, B C. glabrata, C C. tropicalis, D C krusei and E C. parapsilosis

Figure 3: C. albicans germ tube formation 40x
Figure 4: The effect of antifungal on candida spp.
Table 3: Antifungal used of Studied samples
| Antifungal discs | Symbol | Concentration μg\disc |
Clotrimazole | CLO | 50 µg | |
Amphotricin B | AMP | 20 µg | |
Fluconazole | FLU | 25 µg | |
Ketoconazole | KCA | 10 µg |
Table 4: The sensitivity and resistance of isolates of fungal species
Antifungal Candida spp | KCA 10 | FLU 25 | CLO 50 | CC 10 | AMB 20 | NY 100 | |||||||
| No. | S | R | S | R | S | R | S | R | S | R | S | R | |
| C. albicans | 19 | (16) 84 % | (3) 16 % | (12) 63 % | (7) 37 % | (13) 68 % | (6) 32 % | (11) 58 % | (8) 42 % | (0) 0 % | (19) 100% | (6) 32 % | (13) 68 % |
| C. glabrata | 14 | (12) 85 % | (2) 14 % | (10) 71 % | (4) 29 % | (13) 93 % | (1) 7 % | (9) 64 % | (5) 36 % | (2) 14 % | (12) 86 % | (4) 29 % | (10) 71 % |
| C. kruzei | 8 | (8) 100% | (0) 0 % | (5) 62 % | (3) 37 % | (8) 100% | (0) 0 % | (7) 87 % | (1) 12 % | (0) 0 % | (8) 100% | (1) 12 % | (7) 87 % |
| C. parapsilosis | 3 | (3) 100% | (0) 0 % | (2) 67 % | (1) 33 % | (3) 100% | (0) 0 % | (2) 67 % | (1) 33 % | (1) 33 % | (2) 67 % | (1) 33 % | (2) 67 % |
| C. trpicals | 2 | (2) 100% | (0) 0 % | (2) 100% | (0) 0 % | (2) 100% | (0) 0 % | (2) 100% | (0) 0 % | (0) 0 % | (2) 100% | (0) 0 % | (2) 100% |
KCA: Ketoconazole, FLU: Fluconazole, CLO: Clotrimazole, CC: Clotrimazole, AMB: Amphotericin B, NY: Nystatin, S: sensitivity, R: Resistance
The study focused on the causative agent of candidiasis in patients with chronic dialysis patients in the city of Kirkuk- Iraq, and isolated five of Candida species. The Candida albicans was the most common species compared to other isolated. And the use of medical device used for hemodialysis increase the risk of fungal infection.
Rafiq, A. N., and N. B. Rafiq. "Candidiasis." Treasure Island (FL), 2023.
Bongomin, F., et al. "Global and Multi-National Prevalence of Fungal Diseases—Estimate Precision." Journal of Fungi, vol. 3, no. 4, 2017, p. 57.
Mohsin, Z. A. "Antagonistic Activity of Bacteriocin-Producing Lactobacillus against Candida spp." Iraqi Journal of Science, 2021, pp. 2153–2162.
Silva, S., et al. "Adherence and Biofilm Formation of Non-Candida Albicans Candida Species." Trends in Microbiology, vol. 19, no. 5, 2011, pp. 241–247.
Meyer, T. W., and T. H. Hostetter. "Uremia." New England Journal of Medicine, vol. 357, no. 13, 2007, pp. 1316–1325.
Pyrgos, V., et al. "Candida Bloodstream Infections in Hemodialysis Recipients." Sabouraudia, vol. 47, no. 5, 2009, pp. 463–467.
Pfaller, M. A., and D. Diekema. "Epidemiology of Invasive Candidiasis: A Persistent Public Health Problem." Clinical Microbiology Reviews, vol. 20, no. 1, 2007, pp. 133–163.
Lepe-Zúñiga, J. L., et al. "End Stage Renal Disease Lymphopenia; Characterization and Clinical Correlation." Revista Médica Del Instituto Mexicano del Seguro Social, vol. 54, no. 4, 2016, pp. 446–453.
Abbas, S. "Soluble Intercellular Adhesion Molecule 1 and Its Correlation with Some Inflammatory Markers in Hemodialysis Patients." International Journal of Pharmacy Research, vol. 11, no. 3, 2019.
Gulcan, A., et al. "Oral Yeast Colonization in Peritoneal Dialysis and Hemodialysis Patients and Renal Transplant Recipients." Comparative Immunology, Microbiology and Infectious Diseases, vol. 46, 2016, pp. 47–52.
Vaziri, N. D., et al. "Effect of Uremia on Structure and Function of the Immune System." Journal of Renal Nutrition, vol. 22, no. 1, 2012, pp. 149–156.
Nester, E. W., et al. Microbiology McGraw-Hill. Boston, MA, 2001, pp. 90–94.
Perfect, J. R. "The Antifungal Pipeline: A Reality Check." Nature Reviews Drug Discovery, vol. 16, no. 9, 2017, pp. 603–616.
Abood, M. S. "Immunological and Molecular Study of Candida spp Causing Vulvovaginal Candidiasis and the Role of Lactic Acid Bacteria as Probiotic In Vivo and In Vitro." College of Science, University of Baghdad, Iraq, 2014.
de Hoog, G. S., et al. Atlas of Clinical Fungi. 2nd ed., Centraalbureau voor Schimmelcultures, 2000.
Ogba, O. M., et al. "Characterization of Candida Species Isolated from Cases of Lower Respiratory Tract Infection Among HIV/AIDS Patients in Calabar, Nigeria." World Journal of AIDS, vol. 3, no. 3, 2013, pp. 201–206.
Ellis, D. H. Clinical Mycology: The Human Opportunistic Mycosis. Gillingham Printers Pty Ltd., 1994, p. 166.
Sariguzel, F., et al. "Evaluation of CHROMagar Candida, VITEK2 YST, and VITEK® MS for Identification of Candida Strains Isolated from Blood Cultures." Infezioni in Medicina, vol. 23, no. 4, 2015, pp. 318–322.
Nadeem, S. G., et al. "Effect of Growth Media, pH, and Temperature on Yeast to Hyphal Transition in Candida Albicans." 2013.
AL-Bajilan, A. M. "Study of the Inhibitory Effect of Snake Venom Macrovipra Lantana against the Virulence Factor of Vaginal Candida spp." Doctoral Thesis, Tikrit University, Iraq, 2016.
Pieralisi, N., et al. "Oral Lesions and Colonization by Yeasts in Hemodialysis Patients." Journal of Oral Pathology & Medicine, vol. 44, no. 8, 2015, pp. 585–590.
Shareef, S. I., et al. "Antifungal Susceptibility of Oral Isolates of Non-Albicans Candida Species from Chronic Kidney Disease Patients on Hemodialysis." Biochemical and Cellular Archives, vol. 21, no. 2, 2021.
Godoy, J. S. R., et al. "Colonization of the Oral Cavity by Yeasts in Patients with Chronic Renal Failure Undergoing Hemodialysis." Journal of Oral Pathology & Medicine, vol. 42, no. 3, 2013, pp. 229–234.
Kato, A., et al. "Blood Monocyte Count as a Predictor of Total and Cardiovascular Mortality in Hemodialysis Patients." Nephron Clinical Practice, vol. 110, no. 4, 2008, pp. c235–c243.
Syed-Ahmed, M., and M. Narayanan. "Immune Dysfunction and Risk of Infection in Chronic Kidney Disease." Advances in Chronic Kidney Disease, vol. 26, no. 1, 2019, pp. 8–15.
Mohammed, B. L., et al. "Estimation of Esterase Activity and Adhesion Ability in Various Candida Species." AIP Conference Proceedings, AIP Publishing, 2019.
Jabbar, S., and H. Al-Haishawi. "Isolation and Identification of Candida Tropicalis as a Cause of Cutaneous Candidiasis in Kalar District, Iraq." Archives of Razi Institute, vol. 77, no. 4, 2022, p. 1377.
Matare, T., et al. "Experimental Germ Tube Induction in Candida Albicans: An Evaluation of the Effect of Sodium Bicarbonate on Morphogenesis and Comparison with Pooled Human Serum." Biomed Research International, vol. 2017, 2017.
Faria-Ramos, I., et al. "Species Distribution and In Vitro Antifungal Susceptibility Profiles of Yeast Isolates from Invasive Infections during a Portuguese Multicenter Survey." European Journal of Clinical Microbiology & Infectious Diseases, vol. 33, 2014, pp. 2241–2247.
Manhal, F. S., et al. "Urinary Tract Infection in Hemodialysis Patients with Renal Failure." Journal of Faculty of Medicine Baghdad, vol. 54, no. 1, 2012, pp. 38–41.
Ali, B. M. "Identification and Sensitivity of Aerobic Bacteria Isolated from Urine of Chronic Renal Failure Patients." Doctoral dissertation, Department of Microbiology, University of Khartoum, 2009.
Salehei, Z., et al. "Sensitivity of Vaginal Isolates of Candida to Eight Antifungal Drugs Isolated from Ahvaz, Iran." 2012.
Rajeevan, S., et al. "Characterisation and Antifungal Susceptibility Pattern of Candida Species Isolated from Various Clinical Samples at a Tertiary Care Centre in South India." Indian Journal of Microbiology Research, vol. 3, no. 1, 2016, pp. 53–57.
Padmapriya, G. A. A., et al. "Molecular Confirmation of Candida Species Using Self-Designed Primers by PCR." International Journal of Current Microbiology and Applied Sciences, vol. 4, no. 5, 2015, pp. 289–294.
AL-Maliki, R., and Z. AL-Ani. "Antifungal Resistance of Candida Species Isolated from Iraqi Women Infected with Vulvovaginal Candidiasis." Al-Qadisiyah Medical Journal, vol. 7, no. 11, 2011, pp. 117–127.
Lima, G. M. E., et al. "Identification and Antifungal Susceptibility of Candida Species Isolated from the Urine of Patients in a University Hospital in Brazil." Revista do Instituto de Medicina Tropical de São Paulo, vol. 59, 2017.
Lo Re, V., III, et al. "Oral Azole Antifungal Medications and Risk of Acute Liver Injury, Overall and by Chronic Liver Disease Status." American Journal of Medicine, vol. 129, no. 3, 2016, pp. 283–291.
Liu, M., et al. "CYP51A-Based Mechanism of Azole Resistance in Aspergillus Fumigatus: Illustration by a New 3D Structural Model of Aspergillus Fumigatus CYP51A Protein." Sabouraudia, vol. 54, no. 4, 2016, pp. 400–408.
Zomorodian, K., et al. "In Vitro Susceptibility and Trailing Growth Effect of Clinical Isolates of Candida Species to Azole Drugs." Jundishapur Journal of Microbiology, vol. 9, no. 2, 2016.
Berkow, E. L., et al. "Antifungal Susceptibility Testing: Current Approaches." Clinical Microbiology Reviews, vol. 33, no. 3, 2020, pp. 10–1128.
Gandhi, T. N., et al. "Antifungal Susceptibility of Candida against Six Antifungal Drugs by Disk Diffusion Method Isolated from Vulvovaginal Candidiasis." International Journal of Current Research and Review, vol. 7, no. 11, 2015, p. 20.
Mahboob, N., et al. "Disk Diffusion Method in Enriched Mueller Hinton Agar for Determining Susceptibility of Candida Isolates from Various Clinical Specimens." Journal of Dhaka Medical College, vol. 28, no. 1, 2019.
Mohammed, N. A. "Detection of Candida spp. and Other Pathogens Responsible for Vulvovaginitis in Women with Contraceptive Methods." MSc thesis, College of Science, University of Baghdad, 2012.